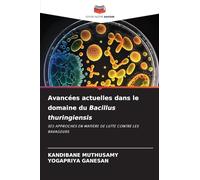

£48.00
amazon.co.uk
Free Delivery

£17.33
Amazon-marketplace.co.uk
Delivery from £16.90

£48.00
amazon.co.uk
Free Delivery

£31.00
amazon.co.uk
Free Delivery

£35.00
amazon.co.uk
Free Delivery

£34.00
amazon.co.uk
Free Delivery

£53.00
amazon.co.uk
Free Delivery

FENBENDAZOLE POUR LA LUTTE CONTRE LES PARASITES CHEZ LES ANIMAUX: L'EFFET DU BENZIMIDAZOLE CONTRE LES PARASITES GASTRO-INTESTINAUX COMME LES ... CHEZ LES ANIMAUX DOMESTIQUES ET LE BÉTAIL
£9.56
amazon.co.uk
Delivery from £2.99

£52.00
amazon.co.uk
Free Delivery

LE GUIDE DU JEU DE PRECINCT 2025: Maîtrisez Les Stratégies De Lutte Contre La Criminalité : Une Présentation Complète Des Procédures Policières, Des Tactiques De Combat Et Des Enquêtes d'Averno City.
£19.99
amazon.co.uk
Free Delivery

£31.00
amazon.co.uk
Free Delivery

Les Chaînes Invisibles de l'Histoire: Lutte et mémoire : le combat contre l'esclavage dans le milieu Sooninké
£22.00
amazon.co.uk
Free Delivery

Arrêtez de ronger les ongles des - formule pour décourager Arrêt De L'Onychophagie Pour | amer intégré dans la Pré Morsure Ongles | Application Facile Lutte Contre sur les ongles et les
£3.29
Amazon-marketplace.co.uk
Delivery from £1.99
£38.00
amazon.co.uk
Free Delivery

Activité larvicide des huiles essentielles sur Aedes aegypti L: Lutte alternative contre les vecteurs
£31.00
amazon.co.uk
Free Delivery

£43.00
amazon.co.uk
Free Delivery

Lutte biologique contre les maladies du blast et du bakanae du riz
£31.00
amazon.co.uk
Free Delivery

£48.00
amazon.co.uk
Free Delivery

Les Marées de Nos Vies: nouveau roman. Une romance poignante sur la côte basque, où la musique du piano, la lutte contre la maladie et des ... que l'amour véritable transcende le temps.
£11.87
amazon.co.uk
Free Delivery

£25.08
amazon.co.uk
Free Delivery

Lutte intégrée contre les mouches des fruits au Pakistan: Techniques intégrées de lutte contre les mouches des fruits et clé d'identification des mouches des fruits sur la base de l'anatomie.
£42.00
amazon.co.uk
Free Delivery

Les Directives sur le droit a l'alimentation: quinze annees de mise en ouvre : Bilan des avancees en matiere de realisation du Programme 2030
£30.31
Whsmith.co.uk
Free Delivery

Suivi, évaluation et apprentissage dans les projets de lutte contre les ravageurs
£21.00
amazon.co.uk
Free Delivery

Connaissance et adoption de la lutte intégrée contre les ravageurs par les riziculteurs
£43.00
amazon.co.uk
Free Delivery

(Se) former à la lutte contre les discriminations racistes: Hors série 3
£17.00
amazon.co.uk
Free Delivery

Lutte alternative contre les nymphes d'aleurodes à l'aide d'extraits de neem: Neem indien : recherche d'alternatives naturelles pour prévenir les ... Bemisia tabaci (biotype B) dans l'agriculture
£30.00
amazon.co.uk
Free Delivery

Lutte contre l'alternariose dans les semences de carottes: Traitements alternatifs
£30.00
amazon.co.uk
Free Delivery

Défis liés à la mise en œuvre des programmes de lutte contre le VIH/sida dans les écoles
£20.00
amazon.co.uk
Free Delivery

Manuel pratique des insectes ravageurs du gombo: Guide de terrain pour l'identification et la lutte contre les ravageurs
£30.00
amazon.co.uk
Free Delivery

Plantes aromatiques allélopathiques pour la lutte contre les maladies de la vigne: Application et capacités
£37.00
amazon.co.uk
Free Delivery

Réaction des agriculteurs face à la lutte intégrée contre les ravageurs dans la culture du chou-fleur
£43.00
amazon.co.uk
Free Delivery

Notes Sur L'ancien Hôtel-dieu De Paris, Relative À La Lutte Des Administrateurs Laïques Contre Le Pouvoir Spirituel Et Aux Abus Et DÃ(c)sordre ... Religieuses Et Les Chapelains De 1505-1789
£17.95
amazon.co.uk
Free Delivery

Notes Sur L'ancien Hôtel-dieu De Paris, Relative À La Lutte Des Administrateurs Laïques Contre Le Pouvoir Spirituel Et Aux Abus Et DÃ(c)sordre ... Religieuses Et Les Chapelains De 1505-1789
£26.95
amazon.co.uk
Free Delivery

Lutte naturelle contre les maladies virales
£25.00
amazon.co.uk
Free Delivery

Politique de la ville et lutte contre les discriminations: 20
£17.00
amazon.co.uk
Free Delivery
🤖 Ask ChatGPT
🛍️ What are the most important purchase criteria?
💰 Tell me the best deals!
📋 Create a short summary!
Informations about "lutte contre les"
Having searched the market for the cheapest buy prices, 56 offers were found for comparison.
Furthermore, a large number of offers in 2 relevant categories with a price range from £3.29 to £103.16 were found.
About "lutte contre les"
- Overall, our search showed 3 different e-shops for your product "lutte contre les", including amazon.co.uk, Amazon-marketplace.co.uk and Whsmith.co.uk.
- If you would prefer an item from a particular brands, you can find 1 e-shops for this product. If you have not yet made a decision, you can also filter your favourite producers and choose between 1 manufacturers.
- The most offers (4) were found in the price range from £17.00 to £17.99.
- Furthermore, other users were also interested in the following product: .
- Personalise your product by choosing one of the 0 coloration.
Don't forget your voucher code:
Report Illegal Concerns
You are about to report a violation based on the EU Digital Services Act (DSA).